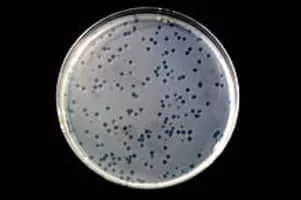

Sinorhizobium
| Use attributes for filter ! | |
| Scientific name | Sinorhizobium |
|---|---|
| Phylum | Proteobacteria |
| Order | Rhizobiales |
| Rank | Genus |
| Higher classification | Rhizobiaceae |
| Class | Alphaproteobacteria |
| Date of Reg. | |
| Date of Upd. | |
| ID | 2304547 |
About Sinorhizobium
Sinorhizobium/Ensifer is a genus of nitrogen-fixing bacteria, three of which have been sequenced.